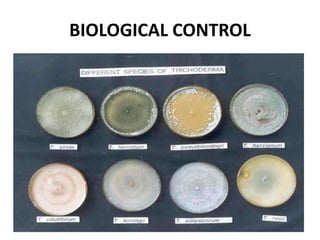
BIOLOGICAL CONTROL

The document provides information on maintaining healthy coconut plantations. It discusses planting materials, spacing, irrigation, integrated nutrient management, and control of diseases. Key recommendations include using good quality seedlings and mother plants, spacing palms 7.5-9 meters apart, irrigating with 45 liters every 4 days, applying organic and chemical fertilizers, controlling pests and diseases through proper sanitation and spraying, and removing diseased or unproductive palms. The main diseases discussed are root wilt caused by a phytoplasma and transmitted by insects, and bud/fruit rot caused by Phytophthora fungi.





![Fungal diseases of coconut
1 Algal leaf spot Cephaleuros virescens
2 Anthracnose Glomerella cingulata = Colletotrichum gloeosporioides [anomorph]
3 Bitten leaf Ceratocystis paradoxa = Chalara paradoxa [anomorph]
4 Bipolaris leaf spot Bipolaris incurvata
5 Black scorch Ceratocystis paradoxa = Chalara paradoxa [anomorph]
6
Bud rot / Nut fall /
Fruit rot
Phytophthora palmivora, P. heveae, P. katsurae, P. nicotianae, P. arecae, Fusarium moniliforme,
Fusarium solani, Graphium sp.
7 Catacauma leaf spot Catacauma mucosum
8 Damping-off Fusarium spp., Phytophthora spp., Pythium spp., Rhizoctonia solani
9 Dry basal rot Ceratocystis paradoxa = Chalara paradoxa [anomorph]
10 Ganoderma butt rot Ganoderma boninense, G. tornatum, G. zonatum
11 Graphiola leaf spot Graphiola phoenicis
12 Gray leaf blight Pestalotiopsis palmarum
13 Koleroga Phytophthora arecae
14 Leaf blight Cytospora palmarum
15 Leaf spots
Alternaria sp., Botryosphaeria disrupta, Capitorostrum cocoes, Cercospora sp., Curvularia lunata,
Cylindrocladium pteridis, Drechslera gigantea, Drechslera halodes, Epicoccum nigrum,
Helminthosporium sp., Macrophoma sp., Macrosporium cocos, Melanconium sp., Mycosphaerella
palmicola
16 Lethal bole rot Marasmiellus cocophilus
17 Lixa grande Sphaerodothis acrocomiae
18 Lixa pequena Phyllachora torrendiella
19 Powdery mildew Oidium sp.
20 Queima das folhas
Botryosphaeria cocogena = Lasiodiplodia theobromae [anomorph]
21 Root rot Fusarium spp., Phytophthora spp., Pythium spp., Rhizoctonia solani,
22 Stem bleeding Ceratocystis paradoxa, Chalara paradoxa
23
Stigmina leaf spot
Stigmina palmivora
24 Thread blight Pellicularia filamentosa, Pellicularia koleroga, Corticium penicillatum
25 Leaf rot
Colletotrichum gloeosporioides, Exserohilum rostratum, Gliocladium vermoeseni, Fusarium solani, F.
moniliforme var. intermedium, Thielaviopsis paradoxa and Rhizoctonia solani](https://image.slidesharecdn.com/coconutcocosnucifera-230421062543-94887990/85/COCONUT-Cocos-nucifera-pptx-6-320.jpg)